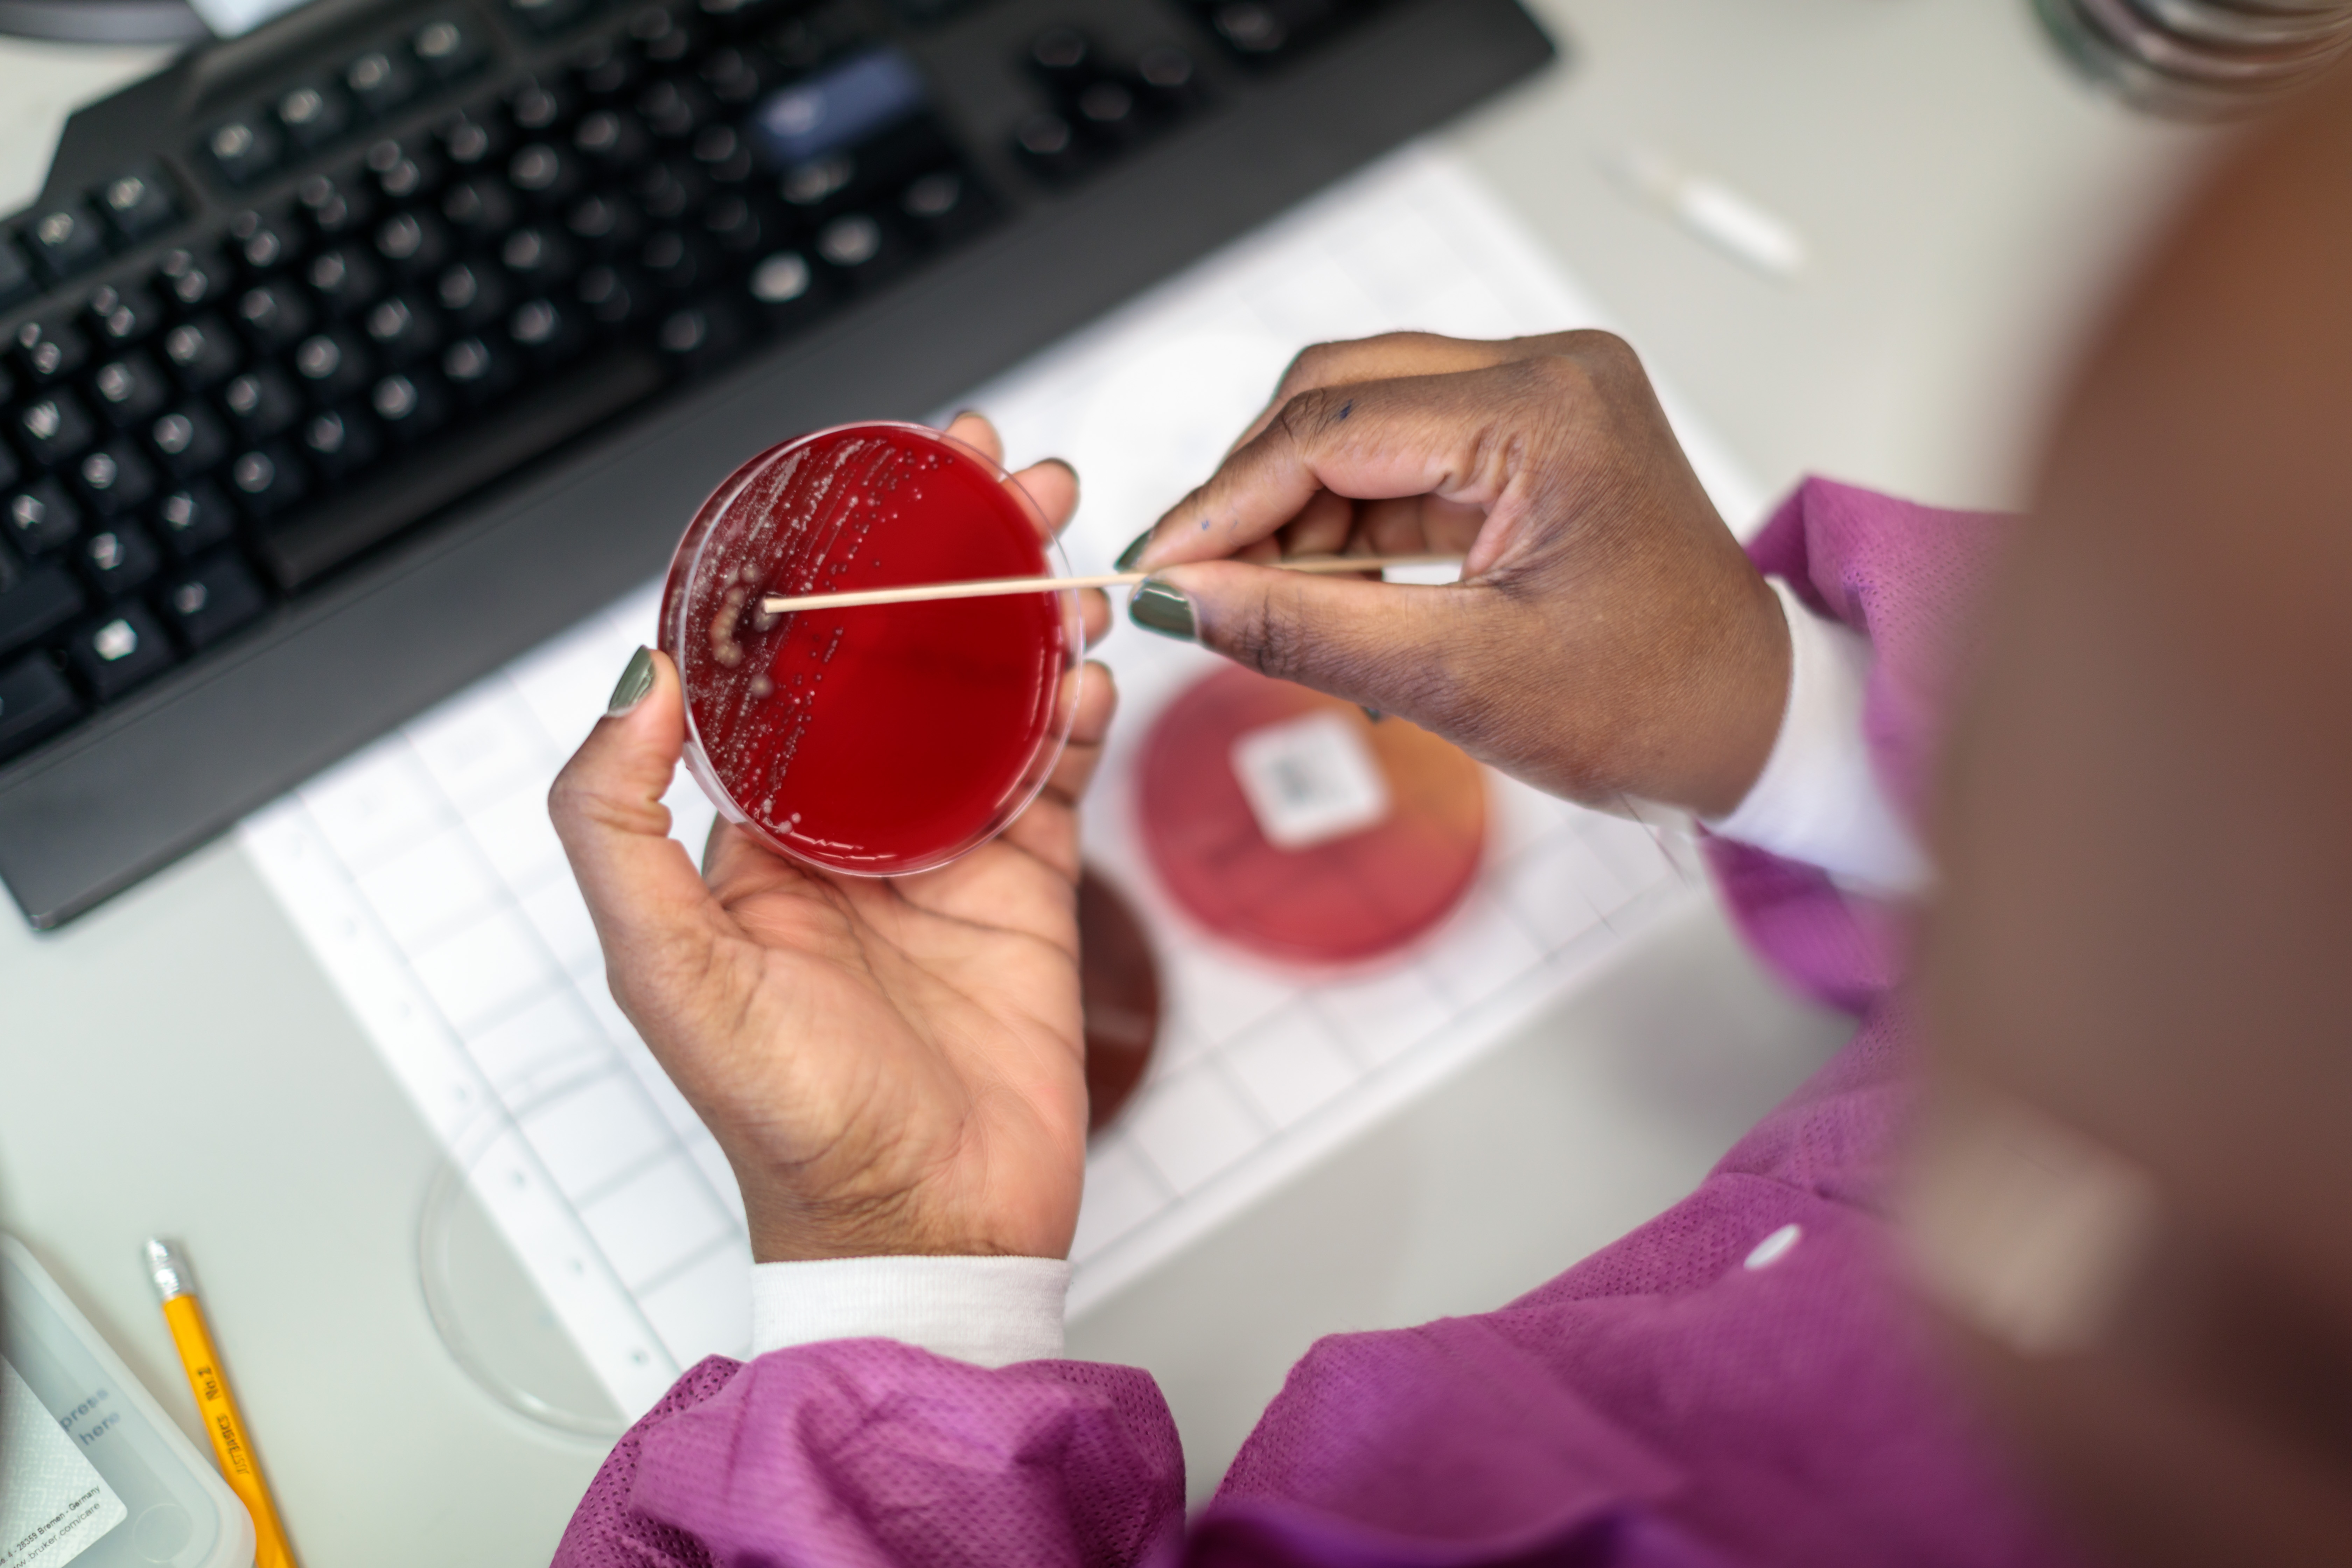

Medical & Public Health Microbiology Fellowship
Overview
The clinical microbiology section of the Division of Laboratory and Genomic Medicine offers a postdoctoral fellowship in medical and public health microbiology. Graduates of the fellowship program are immediately eligible to sit for the American Board of Medical Microbiology (ABMM) examination and if successful, are qualified to direct Clinical Laboratory Improvement Amendments (CLIA)-certified clinical microbiology laboratories throughout the United States.
Program Details
The fellowship training is divided into two years and follows the “Essentials of Training” as prescribed by CPEP. In addition, we have individualized our program and added features unique to the strengths of WashU Medicine and Barnes-Jewish Hospital. For example, we have incorporated rotations in clinical pharmacology, pediatric microbiology and infectious diseases (including general ID, bone and joint ID and transplant ID). In addition, we have an outstanding research environment and faculty and the potential for collaborations in a wide variety of areas, including the microbiome and pathogen genomics.
In addition to scheduled rotations, fellows attend hospital antibiotic stewardship meetings, infection prevention committee meetings and the microbiology-infectious diseases liaison group on a monthly to quarterly basis. They also participate in weekly conferences, including adult and pediatric infectious diseases conferences, microbiology case conferences, “beeper” reports (a discussion of all patient- related questions from the previous week for which they were paged), microbiology lab management meetings and didactic lectures provided by LGM faculty who are experts in microbiology, molecular diagnostics, informatics, and more.
During the second half of their junior year and throughout their senior year, fellows participate in the call rotation where they interact on a daily basis with clinical staff to employ the principles of diagnostic stewardship, answer questions about test interpretation and solve problems related to patient care as it pertains to clinical microbiology.
Finally, during two months of their senior year, in the “acting director rotation,” fellows take responsibility for direction and management of the clinical microbiology and molecular infectious disease laboratories. In addition to training in clinical microbiology, fellows interact on a regular basis with pathology residents and fellows in clinical chemistry, transfusion medicine and molecular diagnostics. Microbiology fellows also participate in a number of laboratory medicine conferences. The result is a broad training experience with knowledge in several areas of laboratory medicine.
The fellowship in medical and public health microbiology has had more than 20 graduates since its inception in 2001 under the direction of Mike Dunne, PhD. All of our program graduates have successfully obtained board certification and are working in the field of clinical microbiology, working in positions in academic, private hospital, and reference laboratories and within industry and public health.
Fellowship applicants must possess an MD, PhD, or other acceptable doctoral degree. Candidates who are not U.S. citizens or permanent residents must be eligible for a J-1, H1B or TN visa to be considered for this program. Permanent residents (green card holders) are eligible.
Training for the fellowship occurs in state-of-the-art facilities at WashU Medicine/Barnes-Jewish Hospital/St. Louis Children’s Hospital. The laboratory is equipped with laboratory automation, several molecular diagnostics platforms, and MALDI-TOF MS. In addition to training at our facility, fellows participate in away rotations at the Wisconsin State Public Health Laboratory, St. Louis University, ARUP and the County Health Department.

Transform Your Passion into Expertise
Applications for the 2027-2029 academic year will be available July 1, 2026.
Application Timeline:
- Online Applications available: July 1, 2026
- Application review window: August 2026 – September 2026
- Interview window: September 2026 – October 2026
- Interviews and offers will take place on a rolling basis until the position is filled.
Apply for The Medical and Public Health Microbiology through CPEP.
Program Director:
Rebekah Dumm, PhD WashU Medicine
Pathology & Immunology
660 S Euclid Avenue
St. Louis, MO 63110
dumm@wustl.edu
Program Contact:
Naomi Rattler
Fellowship Coordinator
Phone: 314-362-3938burr@wustl.edu
Faculty and Trainees
Let’s Connect
Your questions and feedback are the keystones of our continuous improvement. Whether you’re seeking more information about our services, need assistance from our experts, or want to share your experience, we’re here to listen and respond.





